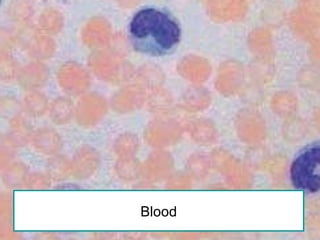
Blood

The document discusses the history and development of the microscope from early magnifying glasses to modern electron microscopes. It describes how early Romans discovered that curved glass lenses could magnify objects and how this led to the eventual invention of compound microscopes with multiple lenses in the 1500s. Key figures like Anton van Leeuwenhoek, Robert Hooke, and Galileo improved microscope design and were able to view previously unseen microscopic life. The modern microscope works by using objective lenses to magnify specimens on slides which are further enlarged through eyepieces.